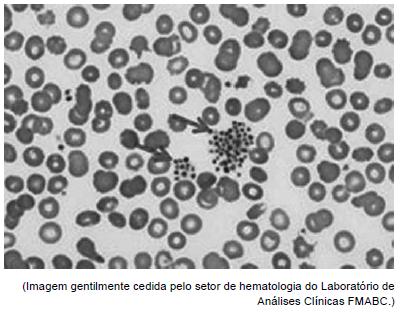
Enunciado 3161244-1

Foram encontradas 1.460 questões.
Paciente masculino, 61 anos apresentou os seguintes resultados:

No setor de triagem do Laboratório de Análises Clínicas são realizados os critérios de aceitabilidade e rejeição das amostras com a finalidade de garantia de um laudo fidedigno e com qualidade. Segundo os resultados apresentados, a amostra deste paciente, ao chegar no setor, encontrava-se em estado
Provas
O exame de urina do tipo 1 é composto por três partes: a física, a química e a sedimentoscopia. Qual elemento do sedimento urinário pode ser comprovado apenas na parte microscópica da sedimentoscopia?
Provas
Dentre as provas funcionais que podem ser realizadas no Laboratório de Análises Clínicas, a alternativa que Não se aplica é:
Provas
A aplicabilidade do corante azul cresil brilhante no Laboratório de Análises Clínicas é a realização da contagem de
Provas
Para as colorações de células em esfregaço de sangue periférico, medula óssea ou para estudo citológico de elementos celulares colhidos por punção, raspagem ou concentrados celulares de derrames cavitários, o corante a ser adotado para esta técnica deve ser:
Provas
Analise a imagem a seguir.
O resultado encontrado no hemograma indica presença de
Provas
A aplicabilidade do exame hemoglobina glicada é determinar
Provas
Gestante teve parto antecipado devido à pré-eclâmpsia (pressão arterial elevada e proteína na urina), e o bebê nasceu ictérico. Este quadro de icterícia deve-se à presença elevada de determinado analito analisado no setor de Bioquímica. Trata-se de
Provas
O sangue fora dos vasos sanguíneos tende a sofrer o processo de coagulação e para mantê-lo líquido no momento pós coleta de sangue, utiliza-se anticoagulantes. O tubo de tampa de coloração roxa é utilizado para coleta de exame de hemograma entre outras provas hematológicas. O nome do anticoagulante pertencente a este tubo é:
Provas
Tênias adultas possuem, em cada anel do seu corpo, os aparelhos reprodutores masculino e feminino desenvolvidos e capazes de fecundação e produção de ovos. Estes anéis são denominados proglotides, que quando contendo ovos desprendem-se do corpo da tênia e são eliminados juntos com as fezes. Todavia, as proglotes das Taenias solium e saginata possuem características diferentes relacionadas à fase grávida que nos auxiliam na identificação da espécie. A afirmação correta é:
Provas
Caderno Container